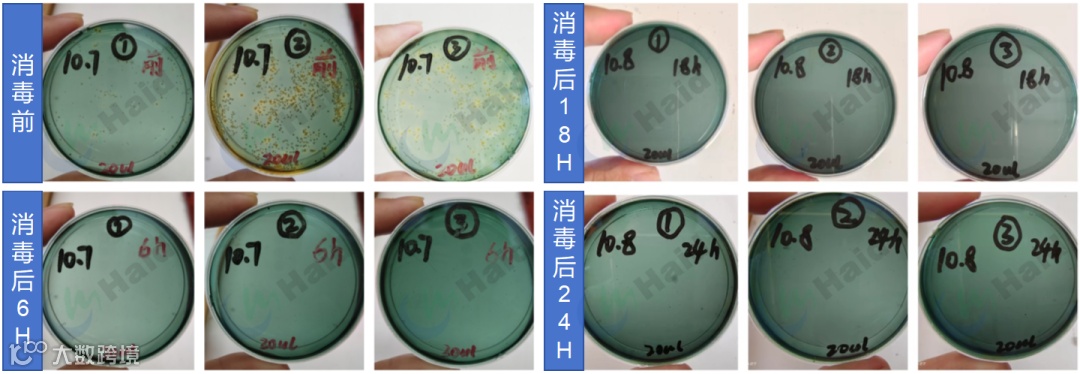

文 | 图
湛江海大服务部 韦寿永
工厂化养殖,弧菌是重中之重,也可防可控,谈“弧“不必色变!
工厂化养殖正在广西沿海区域迅速发展,其高效、稳定和可控性强的特点,将会为广西白虾养殖带来新机遇。但不可否认,工厂化养殖的同样受弧菌病害困扰,对处于发展初级阶段的工厂化养殖来说,影响巨大。特别是今年高致病性弧菌来势汹汹,影响整个养虾行业健康发展,一时谈“弧”色变。
目前,大多数工厂化养殖采用外海水养殖,易携带病原,加上高密度养殖模式,水体有机质含量高,弧菌更容易滋生;特别是在苗期,弧菌爆发危害更大,具体表现为空肠空胃、肝脏萎缩和掉苗损耗,甚至导致排塘。

△弧菌感染时虾体症状
针对工厂化养殖的弧菌问题,湛江海大服务部组织研发工程师驻场工厂化养殖,跟进弧菌来源和爆发规律,总结了一套包含水源处理、过程管理的综合解决方案,以减少工厂化弧菌危害,让养殖更顺利。
①外海水带来;
②虾苗自身携带;
③环境传播感染。
规律1:苗期弧菌会有周期性爆发,间隔时间大概为7天一次;
规律2:在恶劣天气,比如寒潮回温后会有高爆发现象;
规律3:养殖30天开始,体内弧菌容易爆发,此时虾子处在转肝期。

△防城苏老板养殖池弧菌变化情况
1.苗种选择
尽量选择大厂苗种,品控严格,确保苗种质量。
放苗前进行苗种质量检测,规避风险;检测项目包括高致病性弧菌(HLVD)、哈维氏弧菌(VH)、副溶血弧菌(VP)和急性肝胰腺坏死(EMS)等。
2.水源处理
配备蓄水池进行外海水氯处理,消杀弧菌和大部分藻类。
建议蓄水池面积与养殖水体比例为1:2或1:3最佳,满足后期日换水量;使用漂白粉每亩水体40-60斤(有效氯含量10-15ppm)处理,能有效消杀弧菌。
通过沙滤缸,过滤杂质。
1台沙滤缸配备2亩蓄水池为最佳,型号选择上,1台沙缸直径1400毫米、过滤面积1.5㎡、水出口管径dn110,水处理流量能达到60-70方/时。
再经过紫外线照射,高效杀灭弧菌。
选择管道式紫外线消毒器,1台紫外线器配备1000-1500方养殖水体为佳,型号选择管径dn150-dn200,水处理流量为80-100方/时;最后抽水进养殖池。

△水源弧菌检测结果

△水源处理步骤
3.放苗前做水——
清水模式,以菌抑菌
目前大部分工厂化客户苗期使用粉料为主,加上肥水放苗,导致苗期水体容易倒藻,特别是在中造高温期,水浓倒藻现象更为严峻。大量藻类死亡后沉入水底,水体恶化和虾子摄食死藻,弧菌更容易爆发,增加苗期排塘概率。
通过跟进发现,清水放苗模式,可减少藻类波动,弧菌更少更稳定,尤其对苗期养殖作用明显。
虾多宝10kg+益菌多5kg+红糖5kg+自来水100kg密封发酵2天。
放苗前一天使用水精灵0.5克/m³水体+虾多宝发酵液40ppm+强力倍生源1ppm+益水光合素5ppm外泼,遮光控藻,预防水浓倒藻,提高水体总菌含量,抑制弧菌。

△放苗前补菌
4.过程弧菌防控——
水体+虾体补菌,持续抑菌
通过水体补菌,提高有益菌空间占位抑制有害菌繁殖,调节水体酸碱平衡,降低水中氨氮、亚硝酸盐含量。
虾多宝发酵液40ppm每日/次,益水光合素5ppm两天/次。
通过拌喂方法,虾子直接摄入有益菌到肠道,预防肠炎和弧菌。同时护肝健体,提升虾体内免疫组织器官的免疫活性,提高对虾防御病原微生物的侵袭能力。
强力倍生源1包拌20斤料,每日/次;
使用“海大三宝”虾肝宝+VC50+肝泰乐每包拌20斤料,每日/次;
水体和虾体弧菌定期抽样检测弧菌,5-7天/次,防患于未然。
5.弧菌爆发处理——
外消内服,双管齐下
水体弧菌爆发时,使用靓底1ppm消毒,4小时后使用强力倍生源1ppm补菌,补菌48小时后水体弧菌基本得到有效控制。

△靓底+强力倍生源消毒后弧菌变化情况
虾体弧菌爆发时,使用清弧肽+肝泰乐,1包拌20斤料,每日1餐,拌喂3天停4天。
使用第一个周期内,弧菌会有反弹现象,连续使用两个周期,虾体弧菌能稳定控制,效果显著。

△使用清弧肽14天内弧菌变化情况

△使用清弧肽后弧菌变化图
对待弧菌要科学防控,防重于治。
弧菌预防,要关注苗种选择、水源处理、补充有益菌,减少弧菌来源,抑制弧菌生长。弧菌处理,要做好内服外消,让弧菌无处可藏,效果才会更佳。
总的来说,工厂化养殖,弧菌是重中之重,也可防可控,谈“弧“不必色变!
本文系海大农牧(微信号:haid002311)原创,未经授权,一律禁止转载!文章投稿、转载授权,欢迎发邮件到:haidnm@haid.com.cn
✪加海哥微信(haid-services03)
即可加入养殖交流群
及时获得养殖资讯✪


👇 咨询产品可点击"阅读原文"留言

